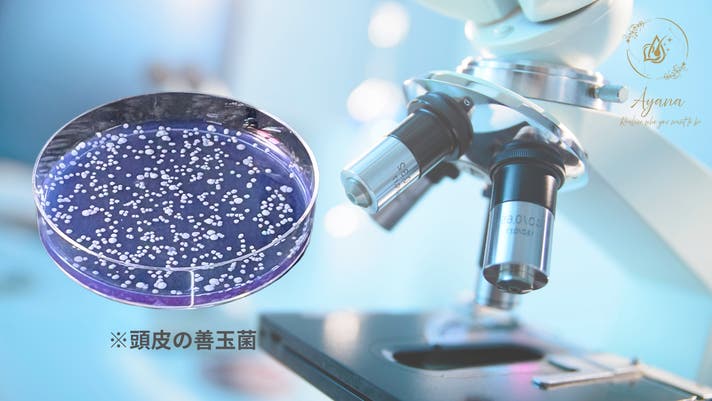

プロジェクト実行者
ストーリー
- 頭皮の善玉菌バランスに着目した マイクロバイオーム発想のスカルプケアローション
- 一人ひとり異なる「頭皮フローラ」に着目。頭皮の状態がわかる【頭皮善玉菌チェックシート】付!
- 菌を味方にする新発想。 善玉菌に寄り添いながら、心地よい頭皮環境へ導くケアを。
私たちはこれまで20年以上、美肌菌※を培養・研究し、
肌本来の力をサポートする化粧品を開発してきました。
研究を重ねるうちに気づいたのは、
頭皮も「皮膚の一部」であり、菌のバランスがとても重要だということ。
そこで、肌に存在する善玉菌※「スタフィロコッカス・エピデルミジス」に着目。
この菌を独自技術で安定配合し、頭皮環境を整えるための新しいアプローチを実現しました。
※スタフィロコッカスエピデルミジス:整肌成分(採取したあなたの善玉菌)


私たちが目指したのは、「誰かのため」ではなく【あなた自身のため】の頭皮ケア。
人の頭皮には、肌と同じように“常在菌”と呼ばれる善玉菌※や日和見菌などが存在しています。
そのバランスは、一人ひとりまったく異なります。
そこで私たちは、あなたの頭皮から善玉菌※を採取し、その菌をもとに製品を製造。
頭皮環境をサポートする“あなた専用”のスカルプケアを実現しました。
※スタフィロコッカスエピデルミジス:整肌成分(採取したあなたの善玉菌)

プロジェクトにご参加いただいた方には、
頭皮の菌の状態をチェックする“頭皮チェックシート”を特典としてご提供。
あなたの肌の皮膚常在菌から善玉菌※を選定し、頭皮チェックシートを作成します。自分の肌を知ることが、肌悩み解決の第一歩。





<保管方法>
・直射日光、高温多湿を避けて保管してください。
・極端に温度変化のある場所(浴室・車内など)での保管はお控えください。
・使用後は必ずキャップをしっかり閉め、清潔にお使いください。
・お子さまやペットの手の届かない場所に保管してください。
・開封後はできるだけお早めにお使いください。
・変色・異臭など、商品の状態に変化が見られた場合は使用を中止してください。
<全成分>
水、ジグリセリン、プロパンジオール、BG、ペンチレングリコール、スタフィロコッカスエピデルミジス、グリチルリチン酸2K、センブリエキス、クララ根エキス、センキュウ根茎エキス、トウキ根エキス、アロエベラ葉エキス、ローマカミツレ花エキス、アルニカ花エキス、オドリコソウ花/葉/茎エキス、オランダガラシ葉/茎エキス、セイヨウキズタ葉/茎エキス、ニンニク根エキス、セイヨウアカマツ球果エキス、ローズマリー葉エキス、ゴボウ根エキス、セージ葉エキス、ソメイヨシノ葉エキス、ビワ葉エキス、オタネニンジン根エキス、クロレラエキス、クズ根エキス、シソ葉エキス、ウンシュウミカン果皮エキス、グレープフルーツ果実エキス、スサビノリエキス、ポリグルタミン酸、コンフリー葉エキス、ユーカリ葉油、トコフェロール、キサンタンガム、PEG-60水添ヒマシ油、カプリリルグリコール、エチルヘキシルグリセリン、クエン酸Na、フェノキシエタノール
<フリー処方>
パラベンフリー/シリコーンフリー/鉱物油フリー/香料フリー/アルコールフリー
内容量: 30mL(約1ヶ月分)
容器仕様: ガラス容器に充填され、アルミパウチに個包装しています。
生産国: 日本製
販売予定価格: 7,700円(税込)
※スタフィロコッカスエピデルミジス:整肌成分(採取したあなたの善玉菌)

2026年1月下旬:Makuake終了
2026年2月上旬:採取キット発送
2026年2月中旬:採取ガーゼ返送後、商品製造開始
2026年2月下旬:商品完成
2026年2月下旬:商品発送予定






私たちが長年向き合ってきたのは、
“人の肌に元々存在する菌(美肌菌※)”の働きです。
個人ごとに異なる菌のバランスが、
肌のコンディションを大きく左右することを研究してきました。
その過程で、ひとつの疑問が生まれました。
「頭皮にも人それぞれの“菌の個性”があるのでは?」
肌と同じように、頭皮にも多様な菌が存在し、
その働きが日々のコンディションに影響する。
この事実から、
「頭皮を整えるには、善玉菌※の力を活かすべき」
という確信にたどり着きました。
そこで私たちは、
あなた自身の“善玉菌※”に着目した、まったく新しい発想のスカルプローションづくりに挑戦。
——「あなた専用の頭皮ケア」という答えを導きました。
ひとりひとり異なる頭皮環境に寄り添うため、
肌由来の善玉菌※(スタフィロコッカス・エピデルミジス)を配合。
すべての人が持つ“もともとの力”をサポートする処方を採用しています。
乾燥や刺激、生活環境などで乱れがちな頭皮バランス。
まずはその土台を整え、
未来の髪が健やかに育つ環境へつないでいきたい——
それが私たちの願いです。
研究の知恵 × 個性に寄り添う発想で、
あなたの未来の髪を支える。
この一滴が、
“自分の頭皮にあったケア”との出会いになりますように。
私たちは『美肌菌由来のスカルプローション(あなたの善玉菌配合)』の製造に 向けて、関係各社と連携しながら、誠意をもってプロジェクトを進めております。
開発にあたり、より良い品質と安定性を追求しているため、
デザインや仕様が一部変更となる可能性がございます。
その際は、速やかに活動レポート等を通じてご報告いたします。
また、本製品は「ご自身の善玉菌(美肌菌)を活用する」という 「ご自身専用の」アイテムであるため、
・製造工程
・検査体制
などに時間を要する場合がございます。
特に、想定以上の応援をいただいた場合、
製造スケジュールや出荷体制に影響し、
お届け時期が遅れる可能性がございます。
その際には、状況をこまめに共有し、
できる限り早いご対応に努めてまいります。
なお、お届けする製品がお肌に合わないと感じられた場合には、
無理に使用を続けず、速やかに使用を中止いただきますようお願いいたします。
本プロジェクトは、皆さまと共に育てていく
新しい「スカルプケアのかたち」への挑戦です。
私たちは最後まで責任をもって取り組んでまいりますので、
あたたかい応援を賜れましたら幸いです。
本プロジェクトにて記載しておりますスケジュールは、
プロジェクト公開時点での予定となります。
※スタフィロコッカスエピデルミジス:整肌成分(採取したあなたの善玉菌)
リスク&チャレンジ
応援購入という仕組みの特性上、 生産状況や物流事情により、 やむを得ず配送が遅れる可能性がございます。 原則として、 配送遅延を理由としたキャンセルはお受けできません。 ただし、 採取キットの配送がリターン予定月から2か月以上遅延した場合に限り、 ご希望の方へキャンセル対応をさせていただきます。 なお、本商品は お客様に採取いただく「採取ガーゼ」を返送いただいてから 製造を開始いたします。 そのため、キャンセル対象となる遅延はあくまで “採取キット配送”に限定される点につきまして、 あらかじめご了承ください。 皆さまのご期待にお応えできるよう、 スタッフ一同、真心を込めて製造・お届けしてまいります。 ------------------------------------------------------------------------------------------------- 【商品等の不具合による返品・交換】 原則として、サポーター都合によるキャンセル・返金は承っておりません。 (サポーター都合のキャンセル不可の例:誤注文、長期不在) ◾️対応条件◾️ 商品の初期不良、またはお届けした商品がご注文内容と異なる場合、到着後14日以内にプロジェクトページの「実行者にメッセージ」よりご連絡ください。状況を確認の上、返金対応、または良品との交換対応をさせていただきます。 ◾️返金額◾️ リターン金額(税込)の全額 ◾️返品送料/再送料◾️ 実行者負担 【返品・交換をお受けできない商品】 ・サポーターの責任により破損、汚損が生じた商品 ・商品のタグ、付属品、パッケージ(箱、袋など)を紛失、破棄された商品 ・事前にご連絡をいただいていない商品 ・商品到着後、15日以上経過した商品
サポーターからの応援コメント
文章のトップに戻る
応援購入する
このプロジェクトはAll in型です。目標金額の達成に関わらず、プロジェクト終了日の2026年01月30日までに支払いを完了した時点で購入が成立します。
決済時に安心システム利用料として2.2%(税抜)がかかります。
インボイス(適格請求書):対応可
【超早割】ELPIDA Ayana 1本(35%OFF)
4,990円(税込)
ELPIDA Ayana 1本(定価:7,700円)
【超早割】4,990円(35%OFF)
【Makuake特典】 頭皮診断シート
※ご購入後、【採取キット】をお届けいたします。
【早割】ELPIDA Ayana 1本(25%OFF)
5,770円(税込)
ELPIDA Ayana 1本(定価:7,700円)
【早割】5,770円(25%OFF)
【Makuake特典】 頭皮診断シート
※ご購入後、【採取キット】をお届けいたします。
※
【Makuake割】ELPIDA Ayana 1本(19%OFF)
6,240円(税込)
ELPIDA Ayana 1本(定価:7,700円)
【Makuake割】6,240円(19%OFF)
【Makuake特典】 頭皮診断シート
※ご購入後、【採取キット】をお届けいたします。
※
【超早割】ELPIDA Ayana 2本(44%OFF)
8,580円(税込)
ELPIDA Ayana 2本 【定価:15,400円】
【超早割】8,580円(44%OFF)
【Makuake特典】 頭皮診断シート
※ご購入後、【採取キット】をお届けいたします。
※
【早割】ELPIDA Ayana 2本(34%OFF)
10,140円(税込)
ELPIDA Ayana 2本 【定価:15,400円】
【早割】10,140円(34%OFF)
【Makuake特典】 頭皮診断シート
※ご購入後、【採取キット】をお届けいたします。
※
【超早割】ELPIDA Ayana 3本(54%OFF)
10,530円(税込)
ELPIDA Ayana 3本 【定価:23,100円】
【超早割】10,530円(54%OFF)
【Makuake特典】 頭皮診断シート
※ご購入後、【採取キット】をお届けいたします。
※
【Makuake割】ELPIDA Ayana 2本(29%OFF)
10,920円(税込)
ELPIDA Ayana 2本(定価:15,400円)
【Makuake割】10,920円(29%OFF)
【Makuake特典】 頭皮診断シート
※ご購入後、【採取キット】をお届けいたします。
※
【早割】ELPIDA Ayana 3本(42%OFF)
13,338円(税込)
ELPIDA Ayana 3本 【定価:23,100円】
【早割】13,338円(42%OFF)
【Makuake特典】 頭皮診断シート
※ご購入後、【採取キット】をお届けいたします。
※
【Makuake割】ELPIDA Ayana 3本(39%OFF)
14,040円(税込)
ELPIDA Ayana 3本(定価:23,100円)
【Makuake割】14,040円(39%OFF)
【Makuake特典】 頭皮診断シート
※ご購入後、【採取キット】をお届けいたします。
※
「Makuake(マクアケ)」は、実行者の想いを応援購入によって実現するアタラシイものやサービスのプラットフォームです。このページは、 コスメ・ビューティーカテゴリの 「頭皮の善玉菌バランスに着目!マイクロバイオーム発想のスカルプケアローション」プロジェクト詳細ページです。